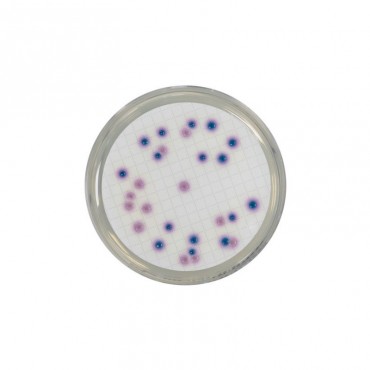
Chromogenic Coliform Agar (CCA) (RTU) Ready to Use culture media Biokar

Compass CC for E.coli & Coliforms (RTU)
CAD$146.66
Environmental testing solutions
FILTER BY
Innovation Diagnostics has everything under one roof to monitor your environment for the presence contaminants that can be detrimental to your production. We offer systems for the collection and detection of contaminants in the air, on production surfaces and non-production surfaces using innovative tools and system to stay in control of your environment.
There are 7 products.
Sort by: